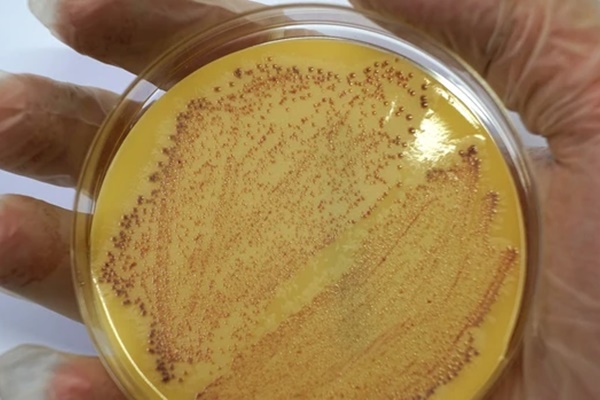
Phổi bẹp dúm, đầy sẹo vĩnh viễn, cô gái 20 tuổi hối hận vì đã làm 1 điều suốt 5 năm-6

Mới đây, một cô gái 20 tuổi đã chia sẻ câu chuyện phổi bị tổn thương nhằm kêu gọi cộng đồng hãy biết chăm sóc sức khỏe lá phổi bằng cách từ bỏ các thói quen xấu.
Xẹp phổi lần đầu tiên
Karlee Ozkurt, 20 tuổi, đến từ Wisconsin, Mỹ, kể trong một ngày đi làm, bỗng nhiên cô bị thở khò khè.
Cô kể: "Đầu tiên, tôi đột nhiên cảm thấy như mình vừa bị giật một cơ ở lưng. Khoảng một giờ sau, tôi bắt đầu thở khò khè. Tôi được cho về sớm - nhưng tôi không nghĩ nó nghiêm trọng đến mức phải đi cấp cứu".
"Nhưng sau một đêm mất ngủ, tôi vẫn đau như cũ và không thở được. Tôi cảm thấy như mình sắp chết. Tôi đến phòng khám không cần hẹn trước và kể cho họ nghe các triệu chứng của tôi - đau ngực, khó thở và đau lưng. Họ đưa tôi đi cấp cứu ngay lập tức".
Vào tháng 11 năm 2021, kết quả chụp X-quang ngực cho thấy phổi phải của Karlee đã xẹp 50%. Vì đây là lần đầu tiên, các bác sĩ đã bơm lại phổi bằng ống tiêm theo cách thủ công.


Karlee nhập viện cấp cứu và phát hiện bị xẹp phổi.
Chứng xẹp phổi là sự xẹp hoàn toàn hoặc một phần của phổi hoặc các thùy phổi. Xẹp phổi xảy ra khi không khí tích tụ giữa phổi và thành ngực, tạo áp lực lên phổi, khiến phổi không thể giãn nở như bình thường.
Tuy nhiên, khi biết Karlee có thói quen hút thuốc lá điện tử, các bác sĩ cảnh báo cô từ bỏ thói quen này nếu không muốn bệnh tái phát.
Phổi đầy sẹo
Sau ba tháng cố gắng bỏ hút thuốc lá điện tử, Karlee cuối cùng vẫn hút trở lại.
Một năm sau, cô lại gặp thêm các vấn đề về sức khỏe.
Cô kể: "Họ nói rằng phổi của tôi xẹp xuống là tự phát - nhưng việc hút thuốc lá điện tử chắc chắn không giúp phòng ngừa bệnh. Vào tháng 11 năm 2022, phổi của tôi lại bị xẹp sau nhiều tháng bị cảm lạnh nặng".
"Nguy cơ tái phát tăng lên mỗi khi xẹp phổi xảy ra - vì vậy lần này, tôi cần phẫu thuật để gây dính màng phổi vào thành ngực. Sau khi chụp CT và phẫu thuật, bác sĩ nhận thấy có nhiều vết sẹo ở phía dưới phổi và dọc theo phổi".

Vào tháng 11 năm 2022, phổi của Karlee bị xẹp lần 2.
"Khi tôi tỉnh lại, tôi hỏi nguyên nhân là gì - và bác sĩ nói chắc chắn rằng là do hút thuốc lá điện tử".
Thói quen xấu bắt nguồn từ thời đi học
Karlee khẳng định hút thuốc lá điện tử là "quyết định tồi tệ nhất" mà cô từng đưa ra và là điều hối tiếc lớn nhất trong cuộc đời cô.
Karlee lần đầu tiên sử dụng thuốc lá điện tử do áp lực từ bạn bè thời trung học. Lúc đó, cô chưa bao giờ nghĩ rằng nó sẽ khiến mình phải nhập viện.
Khi còn là học sinh trung học, cô nghĩ hút thuốc lá điện tử trông thật ngầu và ít độc hại hơn thuốc lá điếu, nhưng trong tháng đầu tiên, cô phải "ép buộc" mình tận hưởng nó sau khi phổi bắt đầu đau.

Karlee khẳng định hút thuốc lá điện tử là "quyết định tồi tệ nhất" mà cô từng đưa ra.
Cô nhớ lại: "Những người bạn lớn tuổi của tôi đã mua cho tôi chiếc vape đầu tiên. Thật vô cùng đau đớn khi thử hít nó. Lẽ ra tôi phải biết ngay từ đầu rằng đó không phải là một điều tốt".
"Nhưng tôi muốn tỏ ra ngầu khi làm việc đó. Tôi 15 tuổi, ngây thơ và muốn gây ấn tượng".
Theo thời gian, Karlee đã quen với cảm giác hút thuốc lá điện tử. Cô thú nhận mình dần trở nên nghiện cảm giác hút thuốc lá điện tử - đặc biệt khi lo lắng hoặc căng thẳng. Càng ngày, cô càng sử dụng nhiều hơn.

Karlee điều trị tại bệnh viện.
Quyết định từ bỏ thói quen xấu
Sau hai lần xẹp phổi, cuối cùng, Karlee đã từ bỏ thuốc lá điện tử vĩnh viễn vào tháng 2 năm nay và hy vọng sẽ không bao giờ tái sử dụng nữa.
Đưa ra lời cảnh báo cho những người khác, cô gái nói: "Bạn không bao giờ nghĩ điều này sẽ xảy ra với mình - nhưng nó đã xảy ra với tôi. Tôi cảm thấy như phổi mình đang bốc cháy".
"Tôi rơi vào cái bẫy nghĩ rằng hút thuốc lá điện tử thật tuyệt - nhưng điều đó thật ngu ngốc. Tôi đã không nhận ra cho đến khi quá muộn".
"Và điều đáng lo ngại là tôi vẫn không biết liệu mình có gây ra thiệt hại gì khác cho cơ thể hay không vì chúng ta chưa nhận thức được những ảnh hưởng lâu dài. Tôi có thể chết ở tuổi 40 hoặc 50 - tất cả chỉ vì thói quen kéo dài 5 năm mà tôi làm theo bạn bè".
Hiện 4,5 triệu người Anh đang hút thuốc lá điện tử, với 15,5% người dưới 25 tuổi hút một lần mỗi ngày.
Theo Dịch vụ Y tế Quốc gia (NHS) Anh, các chuyên gia đặc biệt lo ngại về việc sử dụng thuốc lá điện tử ngày càng gia tăng ở trẻ em, với 1/10 trẻ em từ 11 đến 15 tuổi thường xuyên sử dụng chúng.
Sự phổ biến của các thương hiệu thuốc lá điện tử dùng một lần tại Anh đã khiến Thủ tướng Anh Rishi Sunak tuyên bố hạn chế sử dụng chúng vào năm ngoái. Bộ trưởng Y tế Anh Victoria Atkins cho biết bà tin tưởng lệnh cấm sẽ có hiệu lực vào đầu năm tới.
(Theo Express)
Theo Đời sống pháp luật